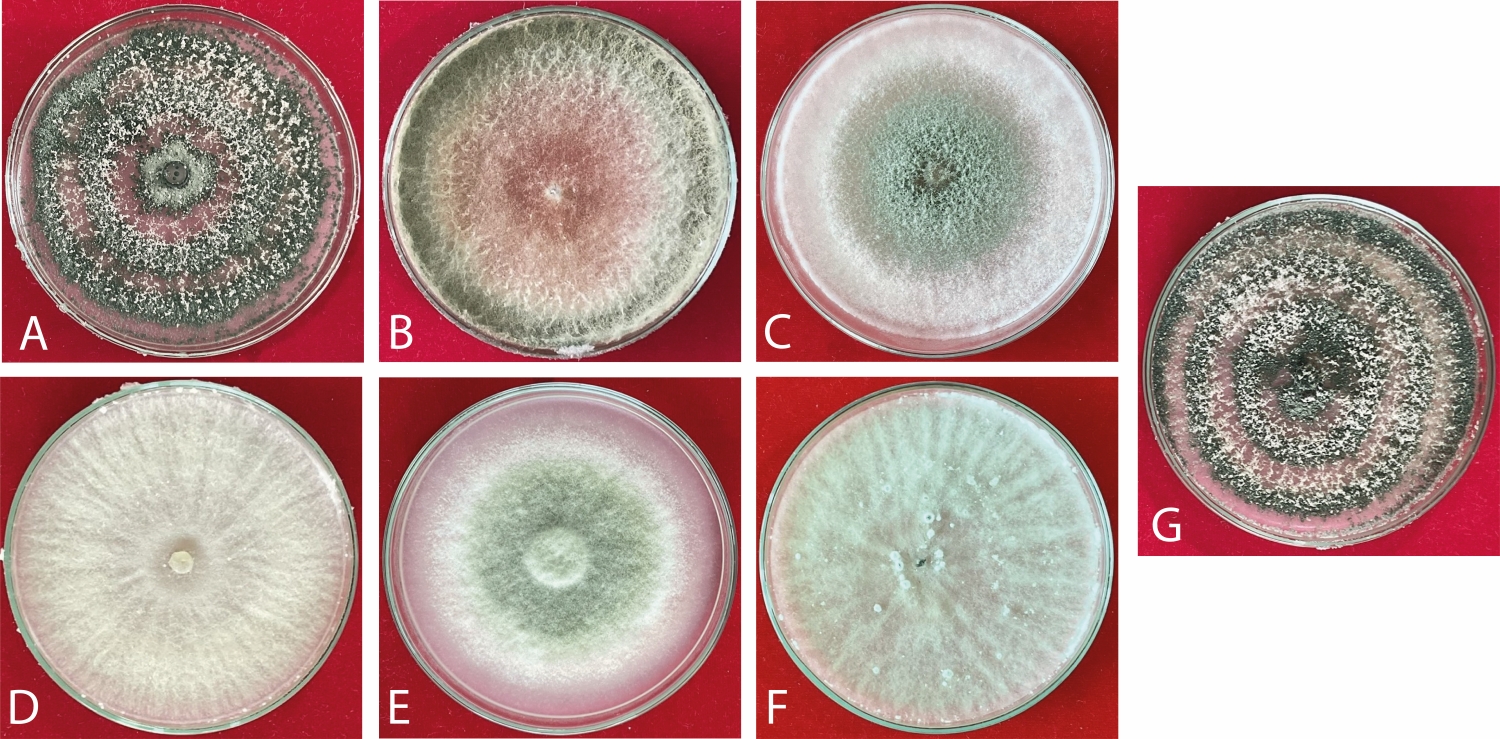
Caracter�sticas culturales de cepas de Trichoderma spp. en medio PDA. (A) F74 suelo, (B) F84 suelo, (C) F78 suelo, (D) F73 ra�z, (E) F19 suelo, (F) F17 hoja, (G) F76 suelo.

Dossier: Producción de Banano, retos y oportunidades
Trichoderma spp. y su influencia en la resiliencia de plantas de plátano ante Ralstonia solanacearum (Smith) filotipo II
Trichoderma spp. and their influence on the resilience of plantain plants to Ralstonia solanacearum (Smith) phylotype II
Trichoderma spp. y su influencia en la resiliencia de plantas de plátano ante Ralstonia solanacearum (Smith) filotipo II
Siembra, vol. 12, núm. 1, e7943, 2025
Universidad Central del Ecuador

Recepción: 23 Febrero 2025
Revisado: 28 Abril 2025
Aprobación: 29 Mayo 2025
Resumen: Ralstonia solanacearum Smith, agente causal del moko bacteriano, representa una de las principales amenazas fitosanitarias para cultivos de musáceas debido a su elevada agresividad y amplia distribución. Con el objetivo de evaluar estrategias de manejo biológico, se determinó el efecto de cepas de Trichoderma spp. sobre la severidad de la enfermedad y el desarrollo agronómico de plantas de plátano (Musa AAB) obtenidas mediante técnica de cultivo de tejidos inoculadas con R. solanacearum. El experimento se estableció bajo un diseño completamente al azar con nueve tratamientos, incluyendo un control sin inoculación (T8) y un control inoculado únicamente con el agente patógeno (T9). Los resultados evidenciaron que T6 (T. lentiforme F19) y T2 (T. harzianum F73) redujeron significativamente la severidad de la enfermedad (p < 0,0001). Asimismo, T6, T5 (T. lixii F17) y T4 (T. afroharzianum F78) promovieron el crecimiento de las plantas, con incrementos significativos en la altura y el diámetro del pseudotallo. No se observaron diferencias significativas en el número de hojas (p > 0,05). Estos resultados confirman el potencial de Trichoderma spp. como agente de biocontrol y bioestimulante en musáceas, constituyendo una alternativa viable dentro de estrategias de manejo integrado para la mitigación de R. solanacearum.
Palabras clave: Ralstonia solanacearum, Trichoderma spp., biocontrol, Moko bacteriano, sostenibilidad agrícola.
Abstract: Ralstonia solanacearum Smith, the causal agent of bacterial moko, represents one of the main phytosanitary threats to Musaceae crops due to its high aggressiveness and wide distribution. To evaluate biological management strategies, the effect of Trichoderma spp. strains on disease severity and agronomic development of plantain plants (Musa AAB) obtained by tissue culture technique and inoculated with R. solanacearum was determined. The experiment was established under a completely randomized design with nine treatments, including a non-inoculated control (T8) and a control inoculated only with the pathogen (T9). Results showed that T6 (T. lentiforme F19) and T2 (T. harzianum F73) significantly reduced disease severity (p < 0.0001). Additionally, T6, T5 (T. lixii F17), and T4 (T. afroharzianum F78) promoted plant growth, with significant increases in plant height and pseudo-stem diameter. No significant differences were observed in leaf number (p > 0.05). These results confirm the potential of Trichoderma spp. as biocontrol agent and biostimulant in Musaceae, constituting a viable alternative within integrated management strategies for the mitigation of R. solanacearum in plantain crops.
Keywords: Ralstonia solanacearum, Trichoderma spp., biocontrol, bacterial Moko, agricultural sustainability.
1. Introducción
El plátano (Musa AAB.) es un cultivo de gran relevancia económica y social en Ecuador. Con una superficie sembrada de aproximadamente 152,654 ha, el país se ha consolidado como uno de los principales exportadores a nivel mundial de plátano fresco, alcanzando ventas de 363.000 t y generando ingresos de US$ 213 millones en 2023 (Sistema de Información Pública Agropecuaria del Ecuador [SIPA], 2017). Las provincias de Manabí y Guayas concentran alrededor del 50% de la producción nacional, creando aproximadamente 65.000 empleos directos e indirectos en el sector (Mendoza Saltos, 2023). Además, el plátano es un componente esencial en la dieta ecuatoriana, con un consumo per cápita de 40 kg al año, lo que representa el 70% de la producción destinada al mercado interno (García et al., 2019; Mendoza Saltos, 2023).
Uno de los principales factores que contribuyen a la reducción del rendimiento agrícola en las musáceas es la alta incidencia de enfermedades. Entre ellas se destacan Mycosphaerella fijiensis Morelet, responsable de la enfermedad denominada sigatoka negra; las pudriciones acuosas provocadas por Dickeya chrysanthemi Burkholder y Pectobacterium carotovorum Jones; y enfermedades virales como el Banana Streak Virus [BSV] y el Cucumber Mosaic Virus [CMV]. Además, en la actualidad, ha aumentado la presencia del patógeno bacteriano Ralstonia solanacearum filotipo II Smith, causante del Moko bacteriano (Clough et al., 2024).
El Moko bacteriano es una de las principales amenazas fitopatológicas a nivel global y representa un riesgo crítico para la sostenibilidad del cultivo de plátano (Agrocalidad, 2013; Delgado et al., 2014). Esta bacteria fitopatógena ataca el sistema vascular, obstruyendo el transporte de agua y nutrientes, lo que conlleva la marchitez y eventual muerte de las plantas infectadas (López-Alvarez et al., 2020). Las pérdidas económicas asociadas a esta enfermedad son alarmantes, especialmente en regiones tropicales como Ecuador, donde los ingresos económicos de un gran número de productores dependen de este cultivo (Gómez-Calvo, 2004; Pardo et al., 2019). Además, la enfermedad afecta la seguridad alimentaria en regiones donde el plátano es un componente fundamental de la dieta diaria (Goszczynska et al., 2000).
Tradicionalmente, las estrategias para el manejo de R. solanacearum se han basado en prácticas culturales, rotación de cultivos y aplicaciones de productos químicos (Pardo et al., 2019). Sin embargo, estas medidas suelen ser costosas, poco sostenibles y, en muchos casos, incapaces de erradicar por completo al patógeno debido a su persistencia en el suelo y su amplia gama de hospedantes. Por ello, se ha intensificado la búsqueda de alternativas sostenibles y efectivas, como el uso de agentes de control biológico [ACB] (Sun et al., 2023).
Entre estos agentes, Trichoderma spp. se han destacado por su capacidad para reducir la incidencia de enfermedades, inducir resistencia sistémica en las plantas y promover su crecimiento (Sharma et al., 2022). Este microorganismo benéfico actúa a través de diversos mecanismos, como el micoparasitismo, la producción de metabolitos secundarios con propiedades antimicrobianas y la estimulación de las defensas naturales de las plantas. Estudios previos han demostrado su eficacia en la supresión de microorganismos patógenos de suelo, incluyendo R. solanacearum, lo que lo convierte en una herramienta prometedora para el manejo integrado de enfermedades (Shashitu, 2021).
En este contexto, el presente estudio tuvo como objetivo evaluar el efecto de Trichoderma spp. en plantas de plátano obtenidas mediante cultivo de tejidos inoculadas con R. solanacearum. Este enfoque no solo busca explorar el potencial de este hongo como agente de control biológico, sino también analizar su impacto en el crecimiento y desarrollo de las plantas bajo condiciones controladas.
2. Materiales y Métodos
2.1. Preparación del inóculo de Trichoderma spp.
Las cepas de Trichoderma spp. forman parte de la colección de microorganismos del Programa de Banano, Plátano y otras musáceas de INIAP, y fueron obtenidas a partir de muestras de plantas de banano, plátano y abacá de las principales zonas productoras de Ecuador (Tabla 1). Para realizar la inoculación de los posibles agentes de biocontrol, las cepas de Trichoderma spp. se sembraron para su activación en placas de Petri con PDA. La obtención de las suspensiones a inocular se realizó agregando 5 ml de agua estéril en cada placa Petri y con una espátula de vidrio Drigalsky se removió suavemente el micelio para desprender los conidios. Las suspensiones se filtraron con gasa para obtener la suspensión de conidios de cada aislado y se determinó su concentración mediante conteos en la cámara de Neubauer, el inóculo se ajustó a una concentración de 1×107 conidios ml-1 (Ramos Martínez, 2006).
| Aislamiento | Origen Botánico | Origen Geográfico | Procedencia |
| Trichoderma asperellum F74 | Plátano | Guayas – Guayaquil | Suelo |
| Trichoderma harzianum F73 | Banano | Santa Elena – Santa Elena | Raíz |
| Trichoderma koningiopsis F84 | Banano | Los Ríos – Babahoyo | Suelo |
| Trichoderma afroharzianum F78 | Banano | Los Ríos – Valencia | Suelo |
| Trichoderma lixii F17 | Plátano | Manabí – El Carmen | Hoja |
| Trichoderma lentiforme F19 | Abacá | Santo Domingo – La Concordia | Suelo |
| Trichoderma azevedoi F76 | Banano | Los Ríos – Vinces | Suelo |
Table 1. Origin of Trichoderma spp. strains.
Las cepas de Trichoderma spp. utilizadas en este estudio correspondieron a aislamientos provenientes de suelo, raíces y hojas, previamente cultivadas en medio PDA para su propagación. Cada cepa posee características morfológicas macroscópicas distintivas, consideradas al momento de su selección como agentes de biocontrol (Figura 1). La cepa F74 (T. asperellum, suelo) se caracteriza por su crecimiento concéntrico definido, micelio algodonoso y coloración verde intensa en el centro, acompañado de exudados oscuros. F84 (T. koningiopsis, suelo) exhibe un aspecto velloso, con centro rosado y halo verde claro, y elevada capacidad de esporulación. F78 (T. afroharzianum, suelo) muestra textura compacta y tonalidades verde azuladas dispuestas en patrón radial. La cepa F73 (T. harzianum, raíz) posee un micelio homogéneo de color blanco, sin pigmentación central. F19 (T. lentiforme, suelo) presenta crecimiento uniforme, con centro verde claro y bordes regulares. F17 (T. lixii, hoja) se distingue por su micelio algodonoso, con transición de color blanquecino en el centro hacia tonalidades verde pálido en los márgenes. Finalmente, F76 (T. azevedoi, suelo) se reconoce por su patrón concéntrico prominente, centro verde oscuro, bordes blancos, textura granulada y producción de exudados oscuros.
Figure 1. Cultural characteristics of Trichoderma spp. strains on PDA medium. (A) F74 soil, (B) F84 soil, (C) F78 soil, (D) F73 root, (E) F19 soil, (F) F17 leaf, (G) F76 soil.
2.2. Confirmación molecular de la identidad de Cepas de Trichoderma spp.
La identificación molecular de las cepas de Trichoderma spp. se llevó a cabo mediante la amplificación y secuenciación de los genes ITS (Internal Transcribed Spacer) y TEF1-α (factor de elongación 1-alfa). Posteriormente, se realizaron PCR utilizando los primers ITS1/ITS4 para la región ITS y EF1-728F/EF1-986R para TEF1-α. Los productos amplificados fueron secuenciados y comparados con bases de datos del NCBI a través de BLASTn. Los análisis filogenéticos confirmaron la identidad de las siguientes especies: Trichoderma asperellum F74, Trichoderma harzianum F73, Trichoderma koningiopsis F84, Trichoderma afroharzianum F78, Trichoderma lixii F17, Trichoderma lentiforme F19 y Trichoderma azevedoi F76. Las secuencias obtenidas mostraron porcentajes de identidad superiores al 99% con secuencias de referencia depositadas en GenBank.
2.3. Tratamiento de vitroplantas con aislados de Trichoderma spp.
La inoculación de los agentes de biocontrol [ACB] se realizó a los ocho días después del trasplante con dosis de 200 mL por planta a una concentración de 1×107 conidios ml-1. La aplicación de los tratamientos (Tabla 2) fue realizada en drench a una frecuencia quincenal, hasta completar tres aplicaciones.
La bacteria R. solanacearum filotipo II proveniente de la colección de patógenos del Programa de Banano, Plátano y otras Musáceas del INIAP, se inoculó 15 días después de la última aplicación de Trichoderma spp. El patógeno se preparó a partir de placas Petri que contenían la bacteria y se diluyó en agua destilada estéril hasta alcanzar el grado de turbidez 0,5 escala MacFarlan (1x 108 UFC ml-1), verificando mediante un espectrofotómetro con el objetivo de que la densidad óptica a 550-660 nm sea de 0,7-1,0, la cual fue inoculada mediante punción al pseudotallo. El avance de la enfermedad se evaluó semanalmente determinando la severidad de las plantas por tratamiento hasta que el 80% de las plantas control presentaran síntomas de marchitez. Para ello se utilizó la escala arbitraria de severidad de 0 a 4 descrita por Bakar et al. (2018) con modificaciones, en la que 0 corresponde a planta sana sin síntomas visibles; 1 a clorosis leve en hojas más viejas; 2 a clorosis pronunciada con necrosis leve y marchitamiento incipiente; 3 a marchitamiento evidente en varias hojas acompañado de necrosis progresiva y caída foliar; y 4 a severa marchitez de toda la planta, colapso del pseudotallo y necrosis generalizada.
| Tratamiento | Descripción |
| T1 | Trichoderma asperellum F74 + Ralstonia solanacearum |
| T2 | Trichoderma harzianum F73 + Ralstonia solanacearum |
| T3 | Trichoderma koningiopsis F84 + Ralstonia solanacearum |
| T4 | Trichoderma afroharzianum F78 + Ralstonia solanacearum |
| T5 | Trichoderma lixii F17 + Ralstonia solanacearum |
| T6 | Trichoderma lentiforme F19 + Ralstonia solanacearum |
| T7 | Trichoderma azevedoi F76 + Ralstonia solanacearum |
| T8 | Solo agua (control negativo) |
| T9 | Inoculación con moko únicamente (control positivo) |
Table 2. Treatment description with Trichoderma spp. and R. solanacearum.
2.4. Diseño experimental
El experimento se diseñó bajo un esquema completamente al azar, con nueve tratamientos (T1-T9) y tres repeticiones por tratamiento. Las unidades experimentales consistieron en grupos de cinco plantas de plátano (Musa AAB.) obtenidas mediante técnicas de cultivo de tejidos, asegurando uniformidad genética y fisiológica.
Los datos obtenidos se sometieron a análisis de varianza [ANOVA] para determinar diferencias significativas entre tratamientos. Se utilizó la prueba de Tukey (p < 0,05) para la comparación de medias. Todos los análisis se realizaron empleando el software estadístico Infostat (2020).
3. Resultados
El análisis estadístico de severidad mostró diferencias significativas entre los tratamientos (p < 0,0001), con un R² ajustado de 0,96, lo que refleja la eficacia de los tratamientos en la variabilidad observada. El control negativo (T8) confirmó la ausencia de enfermedad (media: 0,00), mientras que el control positivo (T9) presentó la mayor severidad (media: 3,82), evidenciando el impacto de R. solanacearum sin ningún tipo de manejo.
En la Figura 2 se pueden observar las plantas de plátano biotizadas con Trichoderma spp., aplicación solo con agua (control negativo) y controladas únicamente con R. solanacearum (control positivo). Se observa un mejor desarrollo vegetativo en las plantas tratadas con Trichoderma spp. en comparación con el control positivo y negativo.

Figure 2. Comparison of vegetative development in banana plants treated with Trichoderma. spp., versus negative and positive controls.
Los tratamientos (T1-T7), constituidos por distintas cepas de Trichoderma spp., redujeron significativamente la severidad de la enfermedad en comparación con el tratamiento T9, en el cual las plantas fueron inoculadas únicamente con R. solanacearum, registrando la mayor severidad (3,82 ± 0,11) (Tabla 3). Los tratamientos T6 (T. lentiforme F19) y T2 (T. harzianum F73) presentaron las menores medias (2,20 ± 0,11), indicando una mayor eficacia en la supresión del patógeno. En contraste, T7 (T. azevedoi F76) mostró una reducción menos pronunciada (2,80 ± 0,11), mientras que T3 (T. koningiopsis F84), T4 (T. afroharzianum F78), T5 (T. lixii F17) y T1 (T. asperellum F74) presentaron valores intermedios (2,23 a 2,59 ± 0,11), reflejando una respuesta variable en la reducción de la severidad. La ausencia de síntomas en el control negativo (T8, sin inoculación; 0,00 ± 0,11) confirma que las diferencias observadas en los tratamientos se deben exclusivamente a la presencia del patógeno.
| Tratamiento | Media | EE | N | Grupo* |
| T9 | 3,82 | 0,11 | 3 | A |
| T7 | 2,80 | 0,11 | 3 | B |
| T1 | 2,59 | 0,11 | 3 | BC |
| T5 | 2,50 | 0,11 | 3 | BC |
| T4 | 2,48 | 0,11 | 3 | BC |
| T3 | 2,23 | 0,11 | 3 | C |
| T2 | 2,20 | 0,11 | 3 | C |
| T6 | 2,20 | 0,11 | 3 | C |
| T8 | -0,00 | 0,11 | 3 | D |
Table 3. Severity analysis in treatments showing statistically different groups.
* Las medias con una letra común no son significativamente diferentes (p > 0,05) / Means with a common letter are not significantly different (p > 0.005).Los resultados evidenciaron diferencias significativas en la altura de las plantas entre los tratamientos (p = 0,0007), destacándose T6 (T. lentiforme F19), T5 (T. lixii F17) y T4 (T. afroharzianum F78), con medias de 25,49 cm, 25,10 cm y 24,52 cm, respectivamente, lo que indica un efecto positivo en la promoción del crecimiento vegetal (Tabla 4). En contraste, el tratamiento T9 (R. solanacearum sin Trichoderma), con 19,5 cm, presentó la menor altura promedio, seguido por T8 (control negativo, sin inoculación) con 20,59 cm, evidenciando la ausencia del efecto bioestimulante observado en los tratamientos con Trichoderma spp. Los tratamientos T1 (T. asperellum F74), T7 (T. azevedoi F76) y T3 (T. koningiopsis F84) presentaron valores intermedios (22,74 cm, 21,76 cm y 21,55 cm, respectivamente), sin diferencias significativas con los tratamientos más efectivos.
| Tratamiento | Media | EE | N | Grupo* |
| T6 | 25,49 | 0,85 | 3 | A |
| T5 | 25,10 | 0,85 | 3 | A |
| T4 | 24,52 | 0,85 | 3 | AB |
| T1 | 22,74 | 0,85 | 3 | ABC |
| T7 | 21,76 | 0,85 | 3 | ABC |
| T3 | 21,55 | 0,85 | 3 | ABC |
| T2 | 21,35 | 0,85 | 3 | ABC |
| T8 | 20,59 | 0,85 | 3 | BC |
| T9 | 19,5 | 0,85 | 3 | C |
Table 4. Plant height analysis by treatment with statistically different groups.
* Las medias con una letra común no son significativamente diferentes (p > 0,05) / Means with a common letter are not significantly different (p > 0.005).El diámetro del pseudotallo fue significativamente influenciado por los tratamientos (p < 0,005), observándose los mayores valores en T6 (T. lentiforme F19) y T5 (T. lixii F17), ambos con 1,72 ± 0,06 cm, superando significativamente al tratamiento T9 (R. solanacearum sin Trichoderma), que presentó el menor diámetro promedio (1,35 ± 0,06 cm) (Tabla 5). Aunque T4 (T. afroharzianum F78) obtuvo un diámetro de 1,67 ± 0,06 cm, su respuesta no difirió estadísticamente de los tratamientos más efectivos. Los tratamientos T1 (T. asperellum F74), T3 (T. koningiopsis F84), T7 (T. azevedoi F76) y T2 (T. harzianum F73) presentaron valores intermedios, con diámetros entre 1,54 y 1,45 cm, sin diferencias significativas entre ellos. El tratamiento T8 (control negativo, sin inoculación) mostró un diámetro de 1,41 ± 0,06 cm, sin diferencias respecto a T2, T3 y T7.
| Tratamiento | Media | EE | N | Grupo* |
| T6 | 1,72 | 0,06 | 3 | A |
| T5 | 1,72 | 0,06 | 3 | A |
| T4 | 1,67 | 0,06 | 3 | AB |
| T1 | 1,54 | 0,06 | 3 | ABC |
| T3 | 1,50 | 0,06 | 3 | ABC |
| T7 | 1,47 | 0,06 | 3 | ABC |
| T2 | 1,45 | 0,06 | 3 | ABC |
| T8 | 1,41 | 0,06 | 3 | BC |
| T9 | 1,35 | 0,06 | 3 | C |
Table 5. Pseudostem diameter analysis by treatment showing statistically different groups.
* Las medias con una letra común no son significativamente diferentes (p > 0,05) / Means with a common letter are not significantly different (p > 0.005).El número de hojas no presentó diferencias significativas entre los tratamientos (p = 0,958), lo que podría atribuirse a la baja sensibilidad de esta variable en las etapas iniciales del experimento. A pesar de ello, los tratamientos con Trichoderma spp. mantuvieron valores comparables a los controles, indicando que no hubo detrimento en el desarrollo foliar (Tabla 6).
| Tratamiento | Media | EE | N | Grupo* |
| T6 | 8,33 | 1,19 | 3 | A |
| T8 | 8,33 | 1,19 | 3 | A |
| T2 | 8,00 | 1,19 | 3 | A |
| T7 | 8,00 | 1,19 | 3 | A |
| T1 | 8,00 | 1,19 | 3 | A |
| T5 | 7,67 | 1,19 | 3 | A |
| T3 | 7,33 | 1,19 | 3 | A |
| T9 | 6,67 | 1,19 | 3 | A |
| T4 | 6,66 | 1,19 | 3 | A |
Table 6. Leaf number analyses per Treatment showing statistically different groups.
* Las medias con una letra común no son significativamente diferentes (p > 0,05) / Means with a common letter are not significantly different (p > 0.005).El modelo estadístico aplicado mostró alta capacidad explicativa en severidad, altura y diámetro, con valores de R² ajustado significativos. No obstante, el bajo R² en el número de hojas subraya la necesidad de interpretar esta variable con precaución en futuras investigaciones.
4. Discusión
El uso de Trichoderma spp. en la agricultura ha demostrado ser una estrategia efectiva tanto en el manejo de enfermedades como en la mejora del crecimiento vegetal, lo que ha impulsado su adopción en sistemas productivos sostenibles. En este estudio, las plantas inoculadas con diferentes especies de Trichoderma mostraron una reducción significativa en la severidad de R. solanacearum, destacándose T6 (T. lentiforme F19) y T2 (T. harzianum F73) como los tratamientos más efectivos (p < 0,0001). Estos resultados son consistentes con lo reportado por Ahmad et al. (2024), quienes documentaron reducciones de hasta un 50% en la incidencia de Ralstonia spp. en cultivos hortícolas tratados con cepas de Trichoderma. La eficacia observada podría atribuirse a mecanismos como la competencia por nicho, la producción de metabolitos antimicrobianos y la inducción de resistencia sistémica.
En condiciones controladas, la aplicación de metabolitos derivados de T2 (T. harzianum) ha demostrado reducir significativamente la carga bacteriana del suelo y disminuir los síntomas de la marchitez bacteriana en cultivos de tomate (Solanum lycopersicum L.) (Yan y Khan, 2021). De manera similar, en este estudio, los tratamientos con Trichoderma no solo mitigaron la severidad de la enfermedad, sino que también promovieron el crecimiento vegetal. Estos hallazgos refuerzan la capacidad bioestimulante de Trichoderma, que ha sido asociada a la producción de fitohormonas y la mejora en la disponibilidad de nutrientes esenciales, según lo documentado por Ramírez-Valdespino et al. (2019).
El diámetro del pseudotallo también se vio influenciado positivamente por la inoculación con Trichoderma. Este incremento podría estar relacionado con una mayor deposición de celulosa y lignina en la pared celular, fortaleciendo la estructura del tallo y proporcionando una mayor resistencia mecánica a la planta (Manzar et al., 2022). En contraste, el número de hojas no presentó diferencias significativas entre los tratamientos (p > 0,05), lo que coincide con estudios previos donde se ha reportado que esta variable es menos sensible en etapas tempranas del cultivo (Damodaran et al., 2020).
5. Conclusiones
Los resultados obtenidos confirman el potencial dual de varias cepas de Trichoderma spp. como agentes de manejo integrado de Ralstonia solanacearum y promotores del crecimiento vegetal. En concreto, las cepas F19 (T. lentiforme) y F73 (T. harzianum) redujeron significativamente la severidad de la marchitez bacteriana (p < 0,0001), mientras que F19, F17 (T. lixii) y F78 (T. afroharzianum) incrementaron la altura de las plantas hasta 25,49 cm y el diámetro del pseudotallo en 1,72 cm, sin que se observaran diferencias significativas en el número de hojas (p > 0,05), lo que indica una baja sensibilidad de esta variable en etapas iniciales.
No obstante, la eficacia demostrada in vitro requiere validación en condiciones de campo, donde la interacción con la microbiota nativa y las variables edafoclimáticas pueden modificar el desempeño de los biocontroladores. En este sentido, la optimización de dosis y formulaciones, así como la combinación de estas cepas con otras estrategias de manejo integrado, resultará esencial para maximizar su impacto en sistemas productivos comerciales de musáceas y garantizar la estabilidad a largo plazo de los efectos bioestimulantes y la contención de posibles adaptaciones de R. solanacearum.
Contribuciones de los autores
Pedro Isaías Terrero Yépez: conceptualización, metodología, administración del proyecto, supervisión, redacción – borrador original.
Nicole Factos: investigación, análisis formal, curación de datos, redacción – borrador original.
Paola Rodulfo: metodología, recursos, investigación, redacción – revisión y edición.
Karina Solis: adquisición de fondos, validación, supervisión, redacción – revisión y edición.
Carlos Molina: supervisión, administración del proyecto, recursos, redacción – revisión y edición.
Karen Rafaela Mayorga: investigación, visualización, redacción – revisión y edición.
Implicaciones éticas
Los autores declaran que no existen implicaciones éticas.
Conflicto de interés
Los autores declaran que no existen conflictos de interés financieros o no financieros que podrían haber influido en el trabajo presentado en este artículo.
Referencias
Agrocalidad. (2013). Ralstonia solanacearum race 2 (Smith 1896) Yabuuchi et al. 1996. Agrocalidad https://www.agrocalidad.gob.ec/wp-content/uploads/2020/05/foc51.pdf
Ahmad, C. A., Akhter, A., Haider, M. S., Abbas, M. T., Hashem, A., Avila-Quezada, G. D., y Abd_Allah, E. F. (2024). Demonstration of the synergistic effect of biochar and Trichoderma harzianum on the development of Ralstonia solanacearum in eggplant. Frontiers in Microbiology, 15, 1360703. https://doi.org/10.3389/fmicb.2024.1360703.
Bakar, R. A. H., Badrun, R., Ahmad, K., y Abu Bakar, N. (2018). Symptomatology and range of the blood disease bacterium A2 HR MARDI strain (Ralstonia syzygii subsp. celebensis) on selected hosts. IOSR Journal of Agriculture and Veterinary Science, 11(9), 71-77. http://psasir.upm.edu.my/id/eprint/74041
Clough, S. E., Elphinstone, J. G., y Friman, V.-P. (2024). Plant pathogenic bacterium Ralstonia solanacearum can rapidly evolve tolerance to antimicrobials produced by Pseudomonas biocontrol bacteria. Journal of Evolutionary Biology, 37(2), 225-237. https://doi.org/10.1093/jeb/voae002
Damodaran, T., Rajan, S., Muthukumar, M., Ram Gopal, Yadav, K., Kumar, S., Ahmad, I., Kumari, N., Mishra, V. K., & Jha, S. K. (2020). Biological management of banana Fusarium wilt caused by Fusarium oxysporum f. sp. cubense tropical race 4 using antagonistic fungal isolate CSR-T-3 (Trichoderma reesei). Frontiers in Microbiology, 11, 595845. https://doi.org/10.3389/fmicb.2020.595845
Delgado, R., Morillo, E., Buitrón, J., Bustamante, A., y Sotomayor, I. (2014). First report of Moko disease caused by Ralstonia solanacearum race 2 in plantain (Musa AAB) in Ecuador. New Disease Reports, 30(1), 23-23. https://doi.org/10.5197/j.2044-0588.2014.030.023
García, R. O., Kerns, J. P., y Thiessen, L. (2019). Ralstonia solanacearum species complex: A quick diagnostic guide. Plant Health Progress, 20(1), 7-13. https://doi.org/10.1094/PHP-04-18-0015-DG
Gómez-Calvo, E. A., Álvarez, E., y Llano, G. (2004). Identificación y caracterización de cepas de Ralstonia solanacearum raza 2, agente causante del moko de plátano en Colombia. Fitopatología Colombiana, 28(2), 71-75. http://ciat-library.ciat.cgiar.org/articulos_ciat/cepas_ralstonia_Moko%20_2.pdf
Goszczynska, T., Serfontein, J. J., y Serfontein, S. (comps.). (2000). Introduction to practical phytobacteriology: A manual for phytobacteriology. SAFRINET. https://ipmil.cired.vt.edu/wp-content/uploads/2014/06/Practical-Bacteriology-Guide-copy.pdf
InfoStat. (2020). InfoStat versión 2020. https://www.infostat.com.ar/index.php
López-Alvarez, D., Leiva, A. M., Barrantes, I., Pardo, J. M., Dominguez, V., y Cuellar, W. J. (2020). Complete genome sequence of the plant pathogen Ralstonia solanacearum strain CIAT-078, isolated in Colombia, obtained using Oxford Nanopore Technology. Microbiology Resource Announcements, 9(22), e00448-20. https://doi.org/10.1128/MRA.00448-20
Manzar, N., Kashyap, A. S., Goutam, R. S., Rajawat, M. V. S., Sharma, P. K., Sharma, S. K., y Singh, H. V. (2022). Trichoderma: Advent of Versatile Biocontrol Agent, Its Secrets and Insights into Mechanism of Biocontrol Potential. Sustainability, 14(19), 12786. https://doi.org/10.3390/su141912786
Mendoza Saltos, M. (2023). Ecuador, primer exportador de plátano fresco en el mundo. Forbes Ecuador. https://www.forbes.com.ec/negocios/ecuador-primer-exportador-platano-fresco-mundo-n64259
Pardo, J. M., López-Alvarez, D., Ceballos, G., Alvarez, E., y Cuellar, W. J. (2019). Detection of Ralstonia solanacearum phylotype II, race 2 causing Moko disease and validation of genetic resistance observed in the hybrid plantain FHIA-21. Tropical Plant Pathology, 44(4), 371-379. https://doi.org/10.1007/s40858-019-00282-3
Ramos Martínez, L. M. (2006). Efecto de hongos endofíticos sobre promoción de crecimiento in vitro plantas de banano y piña. Escuela Agrícola Panamericana Zamorano. https://bdigital.zamorano.edu/handle/11036/932
Ramírez-Valdespino, C. A., Casas-Flores, S., y Olmedo-Monfil, V. (2019). Trichoderma as a model to study effector-like molecules. Frontiers in Microbiology, 10, 1030. https://doi.org/10.3389/fmicb.2019.01030
Sharma, A., Salwan, R., Kaur, R., Sharma, R., y Sharma, V. (2022). Characterization and evaluation of bioformulation from antagonistic and flower inducing Trichoderma asperellum isolate UCRD5. Biocatalysis and Agricultural Biotechnology, 43, 102437. https://doi.org/10.1016/j.bcab.2022.102437
Shashitu, A. (2021). Evaluation of the efficacy of Trichoderma and Pseudomonas species against bacterial wilt Ralstonia isolates of tomato (Lycopersicum species). African Journal of Microbiology Research, 15(5), 262-271. https://doi.org/10.5897/AJMR2021.9523
Sistema de Información Pública Agropecuaria del Ecuador [SIPA]. (2017). Boletín Situacional de banano. https://sipa.agricultura.gob.ec/index.php/situacionales-agricolas/situacional-banano
Sun, Y., Su, Y., Meng, Z., Zhang, J., Zheng, L., Miao, S., Qin, D., Ruan, Y., Wu, Y., Xiong, L., Yan, X., Dong, Z., Cheng, P., Shao, M., y Yu, G. (2023). Biocontrol of bacterial wilt disease in tomato using Bacillus subtilis strain R31. Frontiers in Microbiology, 14, 1281381. https://doi.org/10.3389/fmicb.2023.1281381
Yan, L., y Khan, R. A. A. (2021). Biological control of bacterial wilt in tomato through the metabolites produced by the biocontrol fungus, Trichoderma harzianum. Egyptian Journal of Biological Pest Control, 31(1), 5. https://doi.org/10.1186/s41938-020-00351-9
Información adicional
e-location: e7943
Información adicional
redalyc-journal-id: 6538